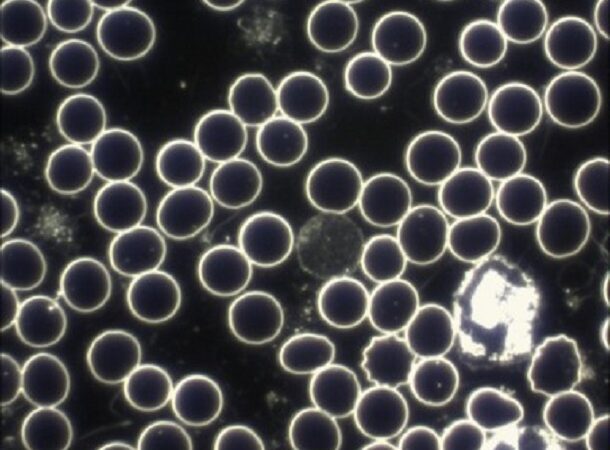

Schlüsselwort Dunkelfeldmikroskopie
Dunkelfeldmikroskopie – Was ist das? Beispiel und Unterschied zur “normalen” Mikroskopie
Bei der Dunkelfeldmikroskopie handelt es sich um ein realtiv beliebtes Diagnoseverfahren in der Alternativmedizin. Bekannt wurde es in der Humanmedizin durch den Zoologen und Entomologen Prof. Dr. Günther Enderlein. Die Dunkelfeldmikroskopie gehört zunächst einmal in die Verfahren der Durchlichtmikroskopie. Anders als in einem Hellfeldmikroskop kann man die Dunkelfeldmikroskopie eher mit der Sicht in einer sternenklaren …